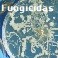
Locales Fungicidas

No products
HIGIENE
-
PERRO
- ADIESTRAMIENTO Perros
- ANTIPARASITARIOS Perros
- Camas Casetas y Jaulas Perros
- Arneses, Bozales, Collares y Correas Perros
- COMEDEROS y BEBEDEROS Perros
- Comida Húmeda Perros
- Comida Seca Perros
- COMPLEMENTOS y SUPLEMENTOS Perros
- COMPORTAMIENTO Perros
- CONDROPROTECTORES Perros
- De paseo Perros
- Descanso Perros
- Higiene Dental y otros Perro
- Juguetes y deporte Perros
- Medicamentos Perros
- Oticos Perro
- Peluquería e Higiene
- ROPA Perros
- SNACKS Perros
- Transporte y Viaje Perros
- ANTIFUNGICO Perro
-
PIENSO PERROS
- CACHORROS - PUPPY
- JUNIOR PERRO
-
FISIOLOGICO - MARCAS
- ACANA PERRO
- APPLAWS PERRO
- GRAIN FREE PERRO
- CALIBRA PERRO
- CESAR PERRO
- DINGO NATURA DIET
- EDGARD & COOPER
- EUKANUBA PERRO
- FRISKIES PERRO
- HILLS CANINE
- IAMS PERRO
- FORZA 10 LEGEND
- LENDA PERRO
- MARS FROLIC Perro
- MAXIMA PERRO
- NATURAL GREATNESS
- NATURAL WOONDLAND
- NATURES VARIETY PERRO
- NUTRO PERRO
- OPTIMA NOVA PERRO
- ORIJEN PERRO
- OWNAT PERRO
- PEDIGREE PERRO
- PURINA DOG CHOW
- PURINA PROPLAN
- PURINA PROPLAN BEYOND PERRO
- ROYAL CANIN PERRO
- SPECIFIC PERRO
- TASTE OF WILD
- TRUE INSTINCT
- VIRBAC HPM PERRO
- SENIOR - MATURE PERRO
- ARTICULAR PERRO
- CARDIOVASCULAR PERRO
- DENTAL PERRO
- GASTROINTESTINAL PERRO
- HEPATICO PERRO
- HYPOALERGENICOS PERRO
- NEUTERED - CASTRADOS PERRO
- OBESIDAD - DIABETES PERRO
- RENAL-URINARIO PERRO
- VET DIETAS EUKANUBA
- VET DIETAS HILL´S
- VET DIETAS PROPLAN
- VET DIETAS ROYAL CANIN PERRO
- VET DIETAS VIRBAC HPM PERRO
-
GATO
- Adiestramiento Gatos
- Antifungico Gato
- Antiparasitarios Gatos
- Arneses, Collares y Correas Gatos
- Camas, Casetas y Jaulas Gatos
- Comederos y bebederos Gatos
- Comida Húmeda Gatos
- Comida Seca Gatos
- Complementos y suplementos Gatos
- Comportamiento Gatos
- Condroprotectores Gatos
- Descanso Gatos
- Higiene Dental y otros Gato
- Juguetes Gatos
- Maltas y hierbas Gatos
- Medicamentos Gatos
- Oticos Gato
- Peluquería e higiene Gatos
- Ropa gatos
- Snacks Gatos
- Transporte y Viaje Gatos
-
PIENSO GATOS
- CACHORROS - KITTEN
-
FISIOLOGICO ADULTO
- ACANA GATO
- APPLAWS GATO
- CALIBRA GATOS
- DINGO GATO
- EUKANUBA GATOS
- GRAIN FREE GATOS
- HILLS FELINE
- IAMS GATO
- MAXIMA GATOS
- NATURAL GREATNESS
- NATURES VARIETY GATO
- NUTRO Fisio GATO
- OPTIMA GATOS
- ORIJEN GATO
- OWNAT GATO
- PEDIGREE GATOS
- PURINA BEYOND GATO
- PURINA CAT CHOW
- PURINA FELIX
- PURINA GOURMET
- PURINA PROPLAN GATO
- ROYAL CANIN GATOS
- SHEBA GATO
- SPECIFIC GATO
- TASTE OF THE WILD
- TRUE INSTINCT
- VIRBAC GATO
- VITAKRAFT GATO
- WHISKAS GATO
- SENIOR - MATURE GATO
- ARTICULAR GATO
- CARDIOVASCULAR GATO
- DENTAL GATO
- DERMA - PIEL Y PELO GATO
- GASTROINTESTINAL GATO
- HAIRBALL - BOLAS DE PELO
- HEPATICO GATO
- HIPERTIROIDISMO GATO
- HYPOALERGENICOS GATO
- NEUTERED-CASTRADOS GATO
- OBESIDAD - DIABETES GATO
- RENAL-URINARIO GATO
- VET DIETAS EUKANUBA GATO
- VET DIETAS HILL´S GATO
- VET DIETAS PROPLAN GATO
- VET DIETAS ROYAL CANIN GATO
- VET DIETAS VIRBAC HPM GATO
- CABALLO
- OTRAS MASCOTAS
- HIGIENE
- MATERIAL
HIGIENE Hay 87 productos.
Subcategorías
-
Humana Higiene de Manos
Jabón y desinfectantes para manos
-
Hogar

-
Locales Detergentes
Limpieza y desincrustacion de materia orgánica en locales, previo a desinfectar
-
Locales Desinfectantes
Para combatir bacterias y virus en locales
-
Locales Fungicidas
Eliminación específica de hongos y levaduras
-
Locales Insecticidas
Para eliminar larvas e insectos voladores, reptantes y trepadores
-
Raticidas
Para eliminar ratas, ratones, topos, etc.
-
AEROBAC SPRAY DESCARGA TOTAL 100 ml...
Aerobact DT. Spray 100 ml Aerosol limipador antiséptico ambientes Desinfección Terminal del Ambiente y de Superficies por Vía Aérea
19,28 € 24,10 € -20%¡Precio rebajado!PRODUCTO EN STOCK -
AGITA GR 1% 1 Kg Granulado Contacto...
AGITA 1% GB Granulado listo para el uso Con azúcar y atrayente sexual Actúa por ingestión y contacto Se aplica esparcido, sobre cartones ligeramente humedos
68,39 € 91,19 € -25%¡Precio rebajado!PRODUCTO EN STOCK -
ANIOSPRAY QUICK Spray 1 Litro Higiene y...
ANIOSPRAY QUICK spray 1 litro Desinfección de acción rápida Para dispositivos médicos no sumergibles, previamente limpios y resistentes al alcohol Listo para usar
45,78 € 57,22 € -20%¡Precio rebajado!PRODUCTO EN STOCK -
AQUASEPTIC INCOLOR 250 ml Antisepsia de...
Aquaseptic Incoloro 250 ml Clorhexidina acuosa 2% Rápida acción antimicrobiana y excelente acción residual Antisepsia general de pieles sensibles
6,23 € 7,79 € -20%¡Precio rebajado!PRODUCTO EN STOCK -
BACTERIGEL G-2 ANTISEPTICO TAPON 750 ml...
Jabón líquido autosecante Frotado higiénico de la piel sana Técnicos sanitarios Personal de industria alimentaria Higiene y desinfección de manos *MENFORSAN HOGAR
10,65 € 13,31 € -20%¡Precio rebajado!PRODUCTO EN STOCK -
BACTERIGEL G-3 HIDROALCOHOLICO Higiene de...
Frotado higiénico de la piel sana Técnicos sanitarios Personal de industria alimentaria Higiene y desinfección de manos *MENFORSAN HOGAR
2,94 € 3,67 € -20%¡Precio rebajado!PRODUCTO EN STOCK -
BAKTOLIN 1 Litro Jabón de manos
Baktolin® puro 1 litro Loción de lavado suave, sin fragancias ni colorantes Adecuado también para pieles sensibles Libre de parabenos
5,48 € 6,85 € -20%¡Precio rebajado!PRODUCTO EN STOCK -
BIOFLOOR FRIEGASUELOS 5 Kg Higiene del Hogar
Biofloor 5 Kg Friegasuelos Elimina malos olores por mascotas Apto para todo tipo de suelos, mármoles, gres, cerámica, porcelanatos, etc.
47,84 € 59,80 € -20%¡Precio rebajado!PRODUCTO EN STOCK -
BIOZUL 1 Litro Repelente Natural de...
BIOZUL 1 litroRepelente natural de insectosFormulado con aceites esenciales
41,55 € 51,94 € -20%¡Precio rebajado!PRODUCTO EN STOCK -
BOLSA RECOGIDA HECES 70 x 20 Unidades...
Vitakraft Dispensador De Bolsas para Desechos Vitakraft Dispensador Bolsitas para recogida de heces del perro 70 Rollos de 20 bolsas Colores surtidos OTRAS PRESENTACIONES
27,36 € 34,20 € -20%¡Precio rebajado!PRODUCTO EN STOCK -
BRINASAN HIGIENE TOTAL 750 ml...
Microbicida a base de ácido hipocloroso Eficaz frente a bacterias Gram+, Gram-, virus, hongos y levaduras Elimina el 99,9999% de microorganismos en menos de 1 minuto Además propiedades antiinflamatorias y cicatrizantes Presentación 750 ml Spray
16,37 € 20,46 € -20%¡Precio rebajado!PRODUCTO EN STOCK -
BRINASAN VETERINARIA Desinfectante esporicida
Microbicida a base de ácido hipoclorosoEficaz frente a bacterias Gram+, Gram-, virus, hongos y levadurasElimina el 99,9999% de microorganismos en menos de 1 minutoAdemás propiedades antiinflamatorias y cicatrizantes
12,26 € 15,32 € -20%¡Precio rebajado!PRODUCTO EN STOCK -
CLOFIX BOLSAS BANDEJA GATO 15 UNIDADES
Bolsas Vitakraft para la bandeja del gato 15 Unidades Facilitan la limpieza y el cambio de arena de forma Rapida e higienica Medidas: 56x37x34 cm
3,33 € 4,16 € -20%¡Precio rebajado!PRODUCTO EN STOCK -
CRYONATUR SPRAY 500 ml Insecticida por frio
Elimina insectos rastreros y voladores por acción del frío A -40 °C, los insectos se paralizan y congelan instantáneamente Sin sustancia activa biocida Permite alcanzar los insectos presentes en grietas y esquinas Espere a que el insecto se asiente antes de rociar a 20 cm
12,93 € 16,16 € -20%¡Precio rebajado!PRODUCTO EN STOCK -
CUCANOR INSECTICIDA DESCARGA TOTAL 150 Hml...
CUCANOR INSECTICIDA DESCARGA TOTAL 150 ml Garajes, trasteros poco frecuentadas por personas Eliminación de insectos voladores y rastreros Efecto insecticida muy prolongado *MENFORSAN HOGAR
14,85 € 18,56 € -20%¡Precio rebajado!PRODUCTO EN STOCK -
DESINCLOR 1 % CLORHEXIDINA 500 ml Higiene...
DESINCLOR 1 % CLORHEXIDINA 500 ml Higiene de Manos Antisepsia de la piel sana. Uso cutáneo y externo. No ingerir. 500 ml
6,56 € 8,20 € -20%¡Precio rebajado!PRODUCTO EN STOCK -
DESINCLOR 1 % CLORHEXIDINA Acuosa 50 ml...
DESINCLOR 1 % CLORHEXIDINA Acuosa 50 ml Higiene de Manos Antisepsia de la piel sana. Uso cutáneo y externo. No ingerir. 50 ml
1,74 € 2,18 € -20%¡Precio rebajado!PRODUCTO EN STOCK -
DETERNET D-50 1 Kg con caña dosificadora...
Deternet® D-50 con caña dosificadora Alto poder desengrasante Formato 1 Kg con bomba dosificadora
6,76 € 8,45 € -20%¡Precio rebajado!PRODUCTO EN STOCK -
DIPACXON D-500 1 Litro Insecticida...
DIPACXON D-500Insecticida Larvicida y Ovicida de uso ganadero
177,66 € 222,08 € -20%¡Precio rebajado!PRODUCTO EN STOCK -
DIPACXON PLUS 1 Litro Insecticida para...
Insecticida para Instalaciones ganaderas
42,73 € 53,41 € -20%¡Precio rebajado!PRODUCTO EN STOCK -
ECOINSECTICIDA 2010 500 ml Insecticida...
Insecticida en emulsión acuosa, exenta de olores Combina eficacia inicial inmediata y efecto residual moderado Eficaz frente a insectos como pulgas, cucarachas, moscas, arañas, hormigas, polillas, ácaros, garrapatas, etc .
16,99 € 21,24 € -20%¡Precio rebajado!PRODUCTO EN STOCK -
ELECTOR Acaricida e Insecticida para...
Control de ácaro rojo aviar Moscas Mosca de los establos Escarabajo del estiércol Presentaciones: 237 ml y 1 litro
194,84 € 243,55 € -20%¡Precio rebajado!FUERA DE STOCK -
EMPAPADORES SABANINDAS Un solo uso Higiene...
Protector absorbente de un solo uso para la cama de sus mascotas Almohadilla Empapador PROTECCIÓN COMODIDAD FUNCIONALIDAD PRACTICIDAD Medidas disponibles: 60 X 40 cm 30 Unidades 60 X 60 cm 25 Unidades 60 X 75 cm 25 Unidades 60 X 90 cm 25 Unidades 60 X 180 cm 25 Unidades
6,50 € 8,12 € -20%¡Precio rebajado!PRODUCTO EN STOCK -
GARRAPATIN Insecticida frente a...
Tratamientos insecticidas contra garrapatas, pulgas, hormigas y otros insectos rastreros Antes de usar el producto léase detenidamente la etiqueta Presentaciones: 400 g y 1 Kg
8,10 € 10,12 € -20%¡Precio rebajado!PRODUCTO EN STOCK -
GEL DERM 500 ml Desinfeccion de manos
Gel Derm 500 ml Gel hidroalcohólico dermatológico Antiséptico, desinfección de manos por fricción
14,52 € 18,15 € -20%¡Precio rebajado!PRODUCTO EN STOCK -
-
GERMINEX CONCENTRALIA 5 Litros...
Limpiador general desinfectante bactericida y fungicida Autorizado para uso ambiental y en industria alimentaria Testado científicamente contra Listeria monocytogenes y Salmonella entérica Uso en colegios, comedores, hoteles, gimnasios, vestuarios, etc. Disponible Pulverizador de 750 ml
67,20 € 84,00 € -20%¡Precio rebajado!PRODUCTO EN STOCK -
GERMINEX Pulverizador 750 ml Accesorio de...
GERMINEX Pulverizador 750 ml Accesosio de Aplicacion
3,39 € 4,24 € -20%¡Precio rebajado!PRODUCTO EN STOCK -
GERMOSAN-NOR BP3 VIRUCIDA SUPERFICIES...
Germosan Nor BP3 Cloruro de didecildimetilamonio 0.3% Desinfectante con actividad virucida Efectivo frente a todos los virus con envoltorio Triple acción: bactericida, fungicida y virucida Uso puro Alta persistencia aromática a eucalipto Para utensilios y suelos, metálicos y esmaltados Formatos: 60, 500, 750 ml y 5 litros *MENFORSAN HOGAR
3,87 € 4,84 € -20%¡Precio rebajado!PRODUCTO EN STOCK -
HELIZYME DETERGENTE ENZIMATICO Para...
Helizyme solución Alto rendimiento en prelimpieza manual y semiautomática de: instrumental quirúrgico endoscopios rígidos y flexibles materiales termolábiles Combinación de tensioactivos ternarios con enzimas proteolíticas Permite tratar eficazmente incluso zonas de difícil acceso de instrumentos complejos
41,24 € 51,55 € -20%¡Precio rebajado!PRODUCTO EN STOCK -
INSTRUNET ENZIMÁTICO EZ+T 1 Litro...
Detergente LÍQUIDO cuatrienzimático concentrado Con enzimas y tensioactivos Limpieza y desincrustacion manual Específico para restos orgánicos de todo tipo en instrumental clínico
37,50 € 46,88 € -20%¡Precio rebajado!PRODUCTO EN STOCK -
INSTRUNET ENZIMÁTICO GPL 1 litro...
INSTRUNET ENZIMÁTICO GPL 1 litro DETERGENTE LÍQUIDO TRIENZIMÁTICO Potente ACCIÓN LIMPIADORA para Instrumental CLÍNICO Y ENDOSCÓPICO. Concentrado, rendimiento 1 litro = 200 litros de solución preparada
32,00 € 40,00 € -20%¡Precio rebajado!PRODUCTO EN STOCK -
INSTRUNET JET PLUS 5 Litros Detergente...
Detergente enzimáticoFormulación especial para restos orgánicos con base proteica y glucí dicaUso manualFormato: 5 litros
111,52 € 139,40 € -20%¡Precio rebajado!PRODUCTO EN STOCK -
ISIVEX 5 Litros Insecticida para...
Principio activo: Diazinon Cipermetrina Insecticida de locales Cucarachas, garrapatas, pulgas moscas y mosquito Especies destino: Caballos, conejos, perros y gatos
169,15 € 211,44 € -20%¡Precio rebajado!PRODUCTO EN STOCK -
JABÓN DERMATOLÓGICO WINTEL 5 Litros Jabón...
Jabón líquido para manos Color amarillo nacarado y fragancia fresca Formulado con suavizantes Ph neutro, no reseca ni irrita la piel Para dispensador modelo Wintel
8,90 € 11,12 € -20%¡Precio rebajado!PRODUCTO EN STOCK -
KORPAL INSECTICIDA SPRAY 300 ml...
insecticida de uso ganaderoAdministracion: Pulverizacion
10,86 € 13,57 € -20%¡Precio rebajado!PRODUCTO EN STOCK -
LARVEX 1 Litro Insecticida para...
LARVEX 1 litroECTOPARASITICIDA, INSECTICIDA Y REPELENTELOCALES E INSTALACIONES GANADERAS
129,44 € 161,80 € -20%¡Precio rebajado!PRODUCTO EN STOCK -
LARVIGEN 48 SC 1 Litro Insecticida...
LARVIGEN 48 SC 1 litro Insecticida, Larvicida-ovicida Locales avícolas y ganaderos, cunicultura, perreras, zoológicos y otros
116,03 € 145,04 € -20%¡Precio rebajado!PRODUCTO EN STOCK -
LARVIVEX COMPLEX 250 ml Insecticida de...
LARVIVEX COMPLEX 250 mlInsecticida, larvicida, ovicida y adulticidaLíquido emulsionable para pulverización de instalacionesComposición: Diflubenzuron y deltametrina
16,66 € 20,82 € -20%¡Precio rebajado!PRODUCTO EN STOCK -
LARVIVEX COMPLEX PLUS 1 Litro Insecticida...
LARVIVEX COMPLEX PLUS 1 litro Insecticida líquido para instalaciones ganaderas Cipermetrina 15 % Diflubenzurón 9 %
66,00 € 82,50 € -20%¡Precio rebajado!PRODUCTO EN STOCK
CONTACTE CON NOSOTROS
ARTÍCULOS RECIENTES